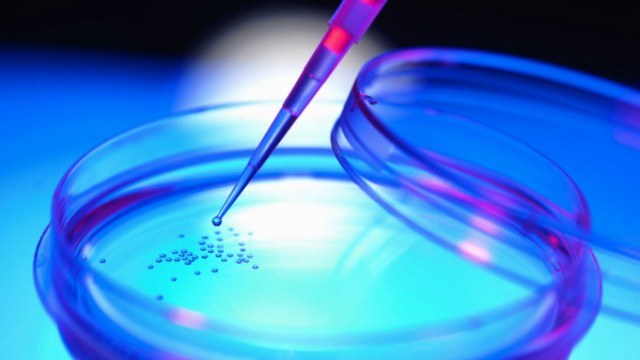

CDKL5: una sigla strana, complessa, ai più sconosciuta, che identifica un gene e una proteina del nostro cervello. Una sigla però ben nota a molti genitori in tutto il mondo, in quanto la Sindrome CDKL5, classificata spesso in modo generico come Sindrome di Rett atipica, o come Variante di Hanefeld della sindrome di Rett, dal nome dello studioso che per primo, nel 1985, ne descrisse le peculiari caratteristiche, è una patologia degenerativa rara che colpisce soprattutto bambine nei primi mesi e anni di vita, provocando gravissimi disturbi neurologici progressivi. Si calcola che in tutto il mondo l’incidenza sia di un caso su 10 mila nuovi nati.
Come la più nota e affine Sindrome di Rett (descritta per la prima volta nel 1966 dallo scienziato austriaco Andreas Rett), la malattia causa gravi ritardi nell'acquisizione del linguaggio e della coordinazione motoria. Spesso la sindrome è associata a ritardo mentale grave o gravissimo. La perdita delle capacità neuromotorie sono generalmente persistenti e progressive. Tale sindrome provoca gravi disabilità, rendendo chi ne è affetto dipendente dagli altri per tutta la vita.
Cosa causa la Sindrome CDKL5
Ma che cosa causa questa malattia e qual è lo stato della ricerca? Sul nostro cromosoma X vi sono diversi geni tra cui anche il gene CDKL5. Tale gene è responsabile, tra l’altro, della produzione di una proteina, che da quest’ultimo prende il nome, particolarmente abbondante nelle cellule del cervello e di importanza fondamentale per un corretto funzionamento del sistema nervoso. Se il gene CDKL5 subisce una mutazione, o una alterazione genetica causa la perdita di un segmento di cromosoma su cui si trova questo particolare gene, la mancata produzione della omonima proteina o la produzione di una proteina alterata, che non adempie più alla sua funzione, porta all’insorgenza dei gravi disturbi neurologici che in genere si manifestano nei primi mesi di vita e che identificano la patologia.
A Bologna si cercherà di fare il punto dello stato della ricerca, delle terapie e dell’assistenza ai piccoli pazienti, sia con interventi scientifici di vari esperti da tutto il mondo, sia con la diretta partecipazione di molte associazioni internazionali di genitori di bambini affetti dalla sindrome CDKL5 nel corso di un convegno in programma dal 25 al 27 aprile al Dipartimento di Fisiologia umana e generale dell'Università di Bologna.
La ricerca Unibo e un primo brevetto
A questi genitori sta cercando di dare nuove risposte un gruppo di ricerca guidato da Elisabetta Ciani del Dipartimento di Scienze biomediche e neuromotorie dell’Università di Bologna, che ha recentemente prodotto una proteina di fusione che pare possa far intravedere progressi, in futuro, nella lotta a questa malattia.
Uno dei problemi finora irrisolti era come far arrivare la proteina CDKL5, che l’organismo non è più in grado di produrre da solo, dove servirebbe: non basta sintetizzarla e iniettarla nell’organismo, non riuscirebbe a superare le barriere di autodifesa del sistema nervoso centrale. La ricerca bolognese è riuscita a trovare il "passepartout" efficace, modificando la proteina CDKL5 agganciandola ad una porzione di proteina virale che la rende ora "permeabile" e le consente di arrivare all'interno del sistema nervoso centrale. L’obiettivo finale è quello di riuscire a veicolare la proteina nel cervello dei pazienti per curarne i disturbi.
Proprio per cercare di trasformare questo interessante risultato di ricerca in possibili cure future, se le verifiche di laboratorio confermeranno questa ipotesi sperimentale, l’Ateneo di Bologna ha avviato le procedure per brevettare quanto finora ottenuto: solo in presenza di un brevetto sarà di fatto possibile coinvolgere gli investitori e le aziende farmaceutiche che possono dare il necessario e fondamentale contributo allo sviluppo e alle fasi cliniche della tecnologia.
"Le associazioni dei genitori hanno fatto tanto, ma oltre non possono andare", spiega Elisabetta Ciani. "Oggi, solo per l’acquisto delle sostanze di laboratorio necessarie, servirebbero varie decine di migliaia di euro, che permetterebbero però di realizzare le prove sperimentali nei tempi dovuti. Come ogni attività di ricerca, i risultati sono incerti, ma quanto ottenuto finora pare essere promettente". Per questo, in parallelo alla protezione brevettuale, ci si sta attivando per individuare le risorse necessarie per portare avanti la ricerca contro questa patologia.